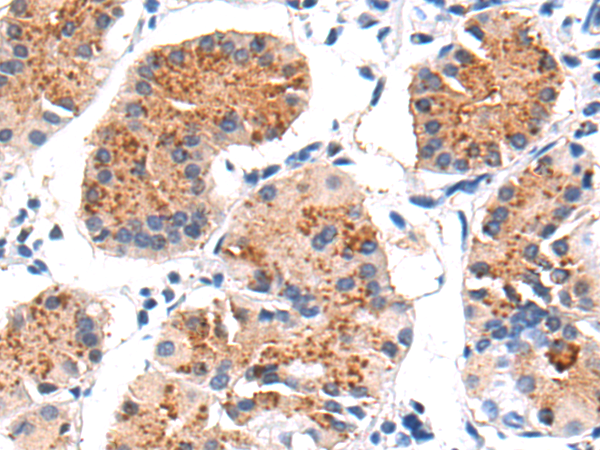

别名:CLG4; MONA; CLG4A; MMP-2; TBE-1; MMP-II应用:WB,IHC
反应种属:Human, Mouse, Rat
规格:50μl/100μl
| Description |
|---|
| This gene is a member of the matrix metalloproteinase (MMP) gene family, that are zinc-dependent enzymes capable of cleaving components of the extracellular matrix and molecules involved in signal transduction. The protein encoded by this gene is a gelatinase A, type IV collagenase, that contains three fibronectin type II repeats in its catalytic site that allow binding of denatured type IV and V collagen and elastin. Unlike most MMP family members, activation of this protein can occur on the cell membrane. This enzyme can be activated extracellularly by proteases, or, intracellulary by its S-glutathiolation with no requirement for proteolytical removal of the pro-domain. This protein is thought to be involved in multiple pathways including roles in the nervous system, endometrial menstrual breakdown, regulation of vascularization, and metastasis. Mutations in this gene have been associated with Winchester syndrome and Nodulosis-Arthropathy-Osteolysis (NAO) syndrome. Alternative splicing results in multiple transcript variants encoding different isoforms. |
| Specification | |
|---|---|
| Aliases | CLG4; MONA; CLG4A; MMP-2; TBE-1; MMP-II |
| Swissprot | P08253 |
| WB Predicted band size | 74 kDa |
| Host/Isotype | Rabbit IgG |
| Storage | Store at 4°C short term. Aliquot and store at -20°C long term. Avoid freeze/thaw cycles. |
| Species Reactivity | Human, Mouse, Rat |
| Immunogen | Synthetic peptide of human MMP2 |
| Formulation | pH7.4 PBS, 0.05% NaN3, 40% Glycerol |
| Application | |
|---|---|
| WB | 1/1000-1/5000 |
| IHC | 1/50-1/200 |
| ELISA | 1/5000-1/10000 |
 |
Gel: 8%SDS-PAGE, Lysate: 40 μg, Lane 1-5: LOVO, NIH/3T3, HT29, MCF7, HUVEC cell lysates, Primary antibody: P04689(MMP2 Antibody) at dilution 1/800, Secondary antibody: Goat anti rabbit IgG at 1/5000 dilution, Exposure time: 2 minutes |
 |
The image is immunohistochemistry of paraffin-embedded Human esophagus cancer tissue using P04689(MMP2 Antibody) at dilution 1/50. (Original magnification: ×200) |
|
The image is immunohistochemistry of paraffin-embedded Human gastric cancer tissue using P04689(MMP2 Antibody) at dilution 1/50. (Original magnification: ×200) |
本公司的所有产品仅用于科学研究或者工业应用等非医疗目的,不可用于人类或动物的临床诊断或治疗,非药用,非食用。
暂无评论
本公司的所有产品仅用于科学研究或者工业应用等非医疗目的,不可用于人类或动物的临床诊断或治疗,非药用,非食用。
 中文
中文 








发表回复